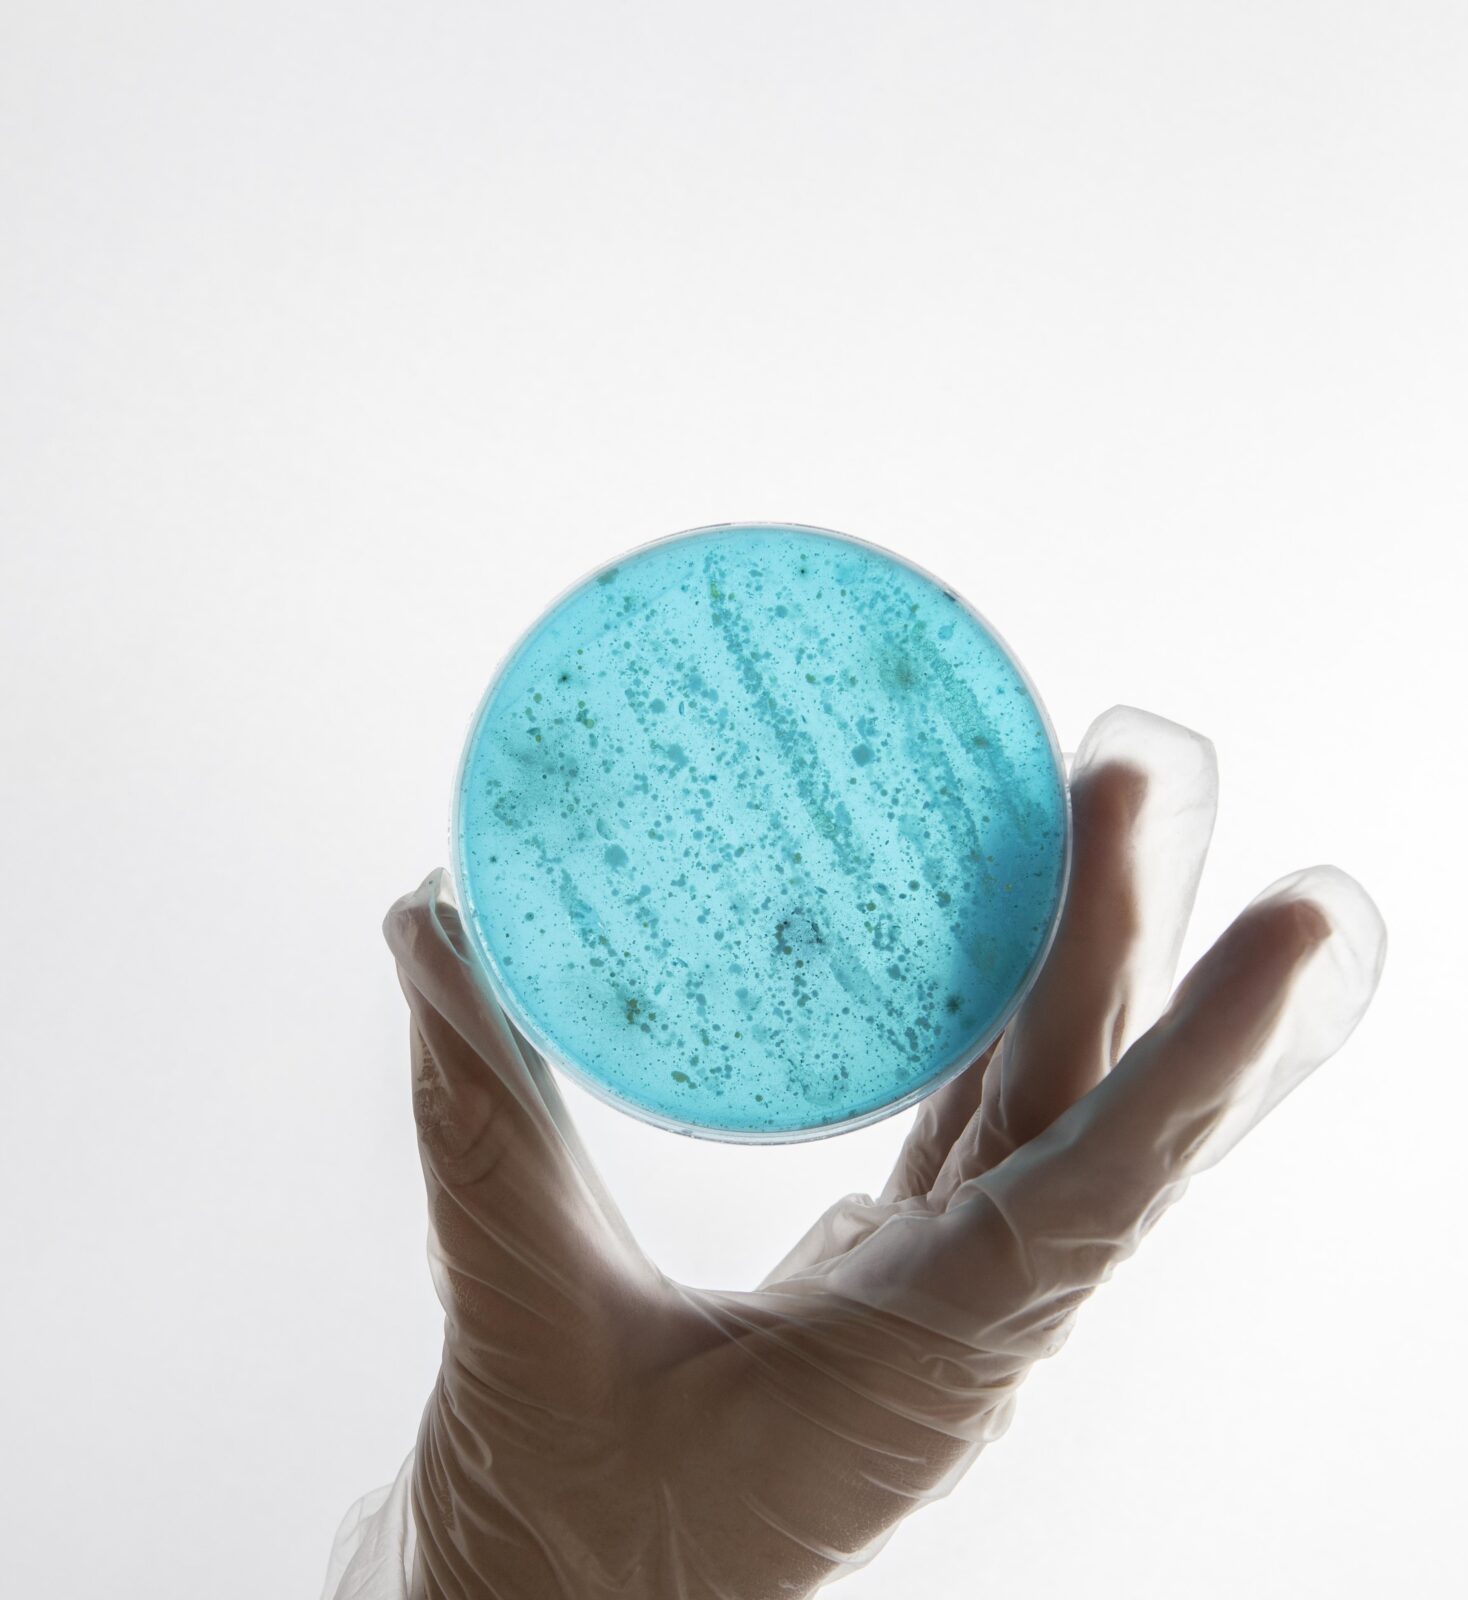

China
Importbedrag stijgt met 32% door meer knoflook en gember
Samen blikken we terug op een jaar vol beweging, verandering en veerkracht. De groente- en fruitsector stond dit jaar niet stil.

GroentenFruit Huis is een vereniging voor en door leden
De vereniging telt 280 leden en staat voor de belangen van bedrijven die actief zijn in de afzet van groenten en fruit. Onze missie is: groenten en fruit de weg naar gezonde generaties.

Samen blikken we terug op een jaar vol beweging, verandering en veerkracht. De groente- en fruitsector stond dit jaar niet stil. Integendeel: juist in een tijd van transitie en maatschappelijke uitdagingen zoals de dalende consumptie en noodzakelijke zichtbare verduurzaming bewezen onze leden en partners opnieuw hun betrokkenheid en wendbaarheid.
Binnen de vereniging stond het jaar 2024 in het teken van vernieuwing en voortbouwen. GroentenFruit Huis heeft samen met haar leden gekeken naar de toekomstbestendigheid van de vereniging. Eén belangrijk onderdeel hiervan was de aanpassing van het contributiestelsel. Het resultaat: één sterk model voor alle leden dat per 1 januari 2025 in werking is getreden. Samen zetten we koers naar de toekomst: met een heldere visie, een stevige organisatie en bovenal een duidelijke ambitie: groenten en fruit de weg naar gezonde generaties.
Gedurende 2024 vroeg de beschikbaarheid van verse groenten en fruit, mede door geopolitieke en klimatologische invloeden, om alertheid en aanpassingsvermogen. Dankzij de kracht van het netwerk en de inzet van velen wisten we de keten functionerend te houden en consumenten te blijven voorzien van gezonde, verse producten. Het Symposium ‘Productbeschikbaarheid niet langer vanzelfsprekend’ droeg bij aan het in kaart brengen van zowel de zorgen als de kansen van de afnemende beschikbaarheid van producten. De zorgen over stijgende voedselprijzen en het bijbehorende beleid werden uitgebreid besproken. Tegelijkertijd kwam ook de kans aan bod dat de veranderende markt de mogelijkheid biedt om tussen telers, afnemers en retailers nieuwe afspraken te maken die de keten ten goede kan veranderen. Met elkaar spreken én werken aan belangrijke vraagstukken omtrent productbeschikbaarheid blijft van groot belang om een toekomstbestendige keten te bouwen waarin beschikbaarheid, kwaliteit en samenwerking hand in hand gaan.
Duurzaamheid is een centraal thema in alles wat GroentenFruit Huis doet. Of het nu gaat om klimaatadaptatie, efficiënter gebruik van grondstoffen of het verder terugdringen van voedselverspilling. Duurzaamheid is geen bijzaak, maar een voorwaarde voor toekomstbestendige groei. Zowel met de doorontwikkeling van de Corporate Sustainability Reporting Directive (CSRD) als met de opzet van de PEFCR zijn er grote stappen gezet. En alhoewel de eisen vanuit de EU wat zijn afgezwakt, blijft de noodzaak voor goede rapportage in ketens noodzakelijk.
Politieke ontmoetingen op uiteenlopende platforms, zoals de Grüne Woche in Berlijn en werkbezoeken van politici aan onze leden, versterkten niet alleen onze zichtbaarheid, maar ook onze betrokkenheid bij beleidsprocessen. In nauwe samenwerking met partners in Nederland en Brussel is verder gebouwd aan strategische coalities en netwerken. Daarmee blijven we werken aan een krachtige positie van de groente- en fruitsector binnen het politieke- en maatschappelijke internationale speelveld.
Voor alle mensen is het van groot belang dat ze dagelijks van groenten en fruit kunnen genieten. Daarbij is het ook qua gezondheid urgenter dan ooit. Uit cijfers blijkt dat de consumptie van verse groenten (-2%) en fruit (-4%) nog steeds daalt. Gezonde voeding verdient een prominente plek op het bord van elke Nederlander; het draagt bij aan preventie van ziekten. In samenwerking met overheden, maatschappelijke organisaties en het bedrijfsleven blijven we bouwen aan een wereld waarin gezonde keuzes de vanzelfsprekende keuzes zijn.
Vooruitkijkend naar het komende jaar ligt onze focus op het continueren en versterken van deze koers. Dit doen we aan de hand van onze drie speerpunten: beheersen van lasten en kosten, productbeschikbaarheid en positionering. We blijven anticiperen op veranderingen met het oog op onze prachtige sector en de maatschappelijke meerwaarde ervan, zoeken actief de verbinding met onze achterban en internationale stakeholders en blijven als vereniging richting geven aan de ontwikkelingen die op ons afkomen. We hebben alle vertrouwen in de kracht van onze sector. Kracht die voortkomt uit samenwerking, ondernemerschap en de gezamenlijke passie voor groenten en fruit.
Namens het bestuur van GroentenFruit Huis wil ik iedereen van harte bedanken die zich in het afgelopen jaar heeft ingezet voor onze gezamenlijke ambities. Uw betrokkenheid maakt het verschil.
Met vertrouwen kijk ik uit naar wat we in het komende jaar weer samen kunnen bereiken.
Cathy van Beek,
Voorzitter GroentenFruit Huis
De leden zijn handelsbedrijven en telersverenigingen die zich bezig houden met de afzet van groenten en fruit. Zij zijn gespecialiseerd in binnenlandse groothandel, import, export, be- en verwerken, verpakken en op- en overslag van groenten en fruit.
Jaarlijks organiseert GroentenFruit Huis vele ledenbijeenkomsten om de leden op de hoogte te brengen van ontwikkelingen, om kennis te delen, te inspireren, betrokkenheid te vergroten, successen te delen en om onderlinge verbindingen te versterken.
In 2024 werden onder andere het GroentenFruit Huis congres, de Algemene Ledenvergadering en het jaarlijkse directiediner georganiseerd.

Eind 2025 bestaat GroentenFruit Huis alweer 10 jaar. In die 10 jaar hebben we samen hard gewerkt om de organisatie te laten groeien en floreren naar de professionele organisatie die we nu zijn. Met aanzien naar buiten toe en een goede reputatie, en met brede en diepgaande kennis over de sector.
Om ook in de komende jaren impact te kunnen maken als vereniging namens de sector moeten we kijken naar de toekomstbestendigheid van de vereniging. Eén onderdeel hiervan is de aanpassing van ons contributiestelsel.
Gedurende de afgelopen jaren heeft er steeds meer consolidatie plaatsgevonden tussen bedrijven. Dit heeft ertoe geleid dat het leden aantal van GroentenFruit Huis aanzienlijk is afgenomen, maar met elkaar is de omzet gestegen. Het huidige contributiestelsel is niet ingericht op deze veranderingen, waardoor de totale contributie-inkomsten afnemen. Bovendien bestaat het huidige stelsel uit een aantal tijdelijke afspraken vanuit de fusies uit het verleden, die structureel moeten worden verankerd.
Op de Algemene Ledenvergadering van 18 december 2024 is de voorgenomen wijziging van het contributiestelsel goedgekeurd. De wijzigingen gaan in per 1 januari 2025.
Meer informatie hierover vindt u op het ledenportaal.

Op woensdag 5 juni vond de Algemene Ledenvergadering (ALV) van GroentenFruit Huis plaats bij Fort de Batterijen in Nieuwegein. Goedkeuring van de jaarrekening, het jaarverslag over 2023, bespreking van verenigingszaken en aandacht voor actuele zaken zoals Public Affairs rondom de verkiezingen. Dit zijn onderwerpen die onder andere aan bod kwamen. Ook werden de aanwezige leden meegenomen in de resultaten van het ledentevredenheidsonderzoek.
Aansluitend op de ALV vond het relatie-event plaats. In de inspiratiesessie van Kevin Weijers werden de aanwezigen gemotiveerd om verandering te omarmen en uitgedaagd om 21 dagen niet te klagen. Annemiek van Vleuten, wereldkampioen tijdrijden, nam de aanwezigen mee in haar “road” naar professioneel wielrenster aan de hand van veerkracht en groei. Hoe verschillende keuzes, de manier van denken en het buiten haar comfort zone treden hebben geleid tot de successen die zij heeft weten te behalen; accept, adapt and move on.
De zonnige dag werd met elkaar afgesloten onder het genot van een hapje en een drankje in de mooie tuin van Fort de Batterijen, met volop gelegenheid om te netwerken en met elkaar van gedachten te wisselen.

Het geslaagde, derde GroentenFruit Huis Congres werd op 16 april 2024 door 135 personen bezocht. Het thema van deze inspirerende dag was: ‘Artificial Intelligence (AI), we moeten er iets mee, maar wat?’. Ruim 25 sprekers verzorgden meer dan twintig workshops, waarmee de dag goed werd gevuld met een grote diversiteit aan onderwerpen voor de leden van GroentenFruit Huis.
De inspirerende keynote van Job van den Berg van AI.nl – The AI Group zorgde ervoor dat de deelnemers direct goed in de materie zaten. Van den Berg liet zien hoe een aantal bedrijven AI inzet om logistieke processen te optimaliseren of verspilling tegen te gaan, en hij gaf handige tips voor AI-tools waar de meesten nog nooit van hadden gehoord.
Aansluitend konden de deelnemers hun eigen dagprogramma samenstellen door de keuze uit tal van workshops, uit elke ambitie van GroentenFruit Huis: Gezondheid, Duurzaamheid, Markt en Economie, Sociaal en Voedselveiligheid. Ook kwam de rol van AI bij het verkrijgen van marktinformatie aan de orde. Thema’s als EU-wetgeving, psychologische veiligheid, het vergroten van marktinzicht en de toepassing van AI in Voedselveiligheid passeerden de revue.
Voor meer informatie over het GroentenFruit Huis Congres kunt u verder lezen op het ledenportaal.

In 2024 werd door GroentenFruit Huis voor de tweede keer de Impact Award uitgereikt aan een medewerker van één van haar leden. Deze award is voor een persoon binnen onze ledengroep, die zich op bijzondere wijze heeft ingezet voor de sector ofwel het verschil heeft gemaakt in het belang van alle leden.
Aan het ontvangen van deze Impact Award zitten een aantal criteria:
De GroentenFruit Huis Impact Award 2024 is uitgereikt aan Arie van der Linden – Head of Quality bij Bakker Centrale Inkoop
Voor meer informatie over de GroentenFruit Huis Impact Award kunt u verder lezen op het ledenportaal.

Het achtste directiediner, dat plaatsvond op woensdagavond 6 november 2024, stond in het teken van verandering en duurzaamheid. Met een inspirerende keynote door Floris Alkemade, architect, oud-Rijksbouwmeester en auteur, bracht de avond een krachtige boodschap: de toekomst van de groente- en fruitsector ligt in onze handen, en er is werk aan de winkel.
Floris Alkemade nam de aanwezigen mee in een reis langs actuele uitdagingen en kansen voor de sector. Onder het thema “Meer met minder” benadrukte hij de noodzaak om flexibel te anticiperen op veranderingen, en om niet alleen te streven naar kostenbesparing maar ook naar weerbaarheid.
“Duurzaam voedsel wordt de komende jaren een van de sleutels tot positieve verandering,” stelde Alkemade. Hij riep op om verder te kijken dan verbetering van bestaande processen. Alleen door verbeeldingskracht in te zetten en radicaal anders te denken kunnen we echte vooruitgang boeken.
Het directiediner liet zien dat de sector klaar is voor de toekomst – een toekomst waarin we samen het verschil kunnen maken, en waarin ‘meer met minder’ centraal mag staan.
Voor meer informatie over het directiediner kunt u verder lezen op het ledenportaal.
19 – 28 Grüne Woche
01 HR-dag
06 Event ‘Op weg naar een Gezonde Voedselomgeving
7 – 9 Fruit Logistica Berlijn
07 Seminar: ‘Hoe Nederland werkt aan gewaardeerd, gezond en veilig voedsel’
08 Seminar: ‘Green Fresh Logistics’
07 Vrouwen en Voedsel
21 Plenaire bijeenkomst Uireka
08 Informatiebijeenkomst importeurs (CIEDL)
9 Ledenbijeenkomst Fruit
17 GroentenFruit Huis congres
21 Start campagne: Groene Kracht Vooruit
25 Cursus Marktanalyse Groenten en Fruit
07 AGF Trendcafé op bezoek bij Gearbox
08 Themamiddag arbeidsmarkt, cao en pensioen
14 EU-Plant Debat
03 CSRD Software Platform Bijeenkomst
05 Algemene Ledenvergadering GroentenFruit Huis
11 Kennisbijeenkomst Voedselveiligheid
18 AGF Trendcafé op bezoek bij Concept Factory
27 Young Business Club
01 Bijeenkomst Vers op het Spoor
01 Informatiebijeenkomst programma Gezonde Lunch
4 – 6 Fruit Logistica Asia
02 Informatiebijeenkomst Pensioentransitie
03 NIMA AGF Marketing Event
8 – 10 Fruit Attraction Madrid
09 Seminar Fresh on Track
10 Groentecongres
12 NIMA Foodchain & Agrimarketing bijeenkomst
06 Directie diner GroentenFruit Huis
06 Webinar ‘CSRD uitgelegd: Verwachtingen en kansen voor het MKB’
12 Symposium ‘Productbeschikbaarheid’
13 Young Business Club
04 Algemene Ledenvergadering GroentenFruit Huis
10 CSRD-netwerkbijeenkomst
14 Tweede Algemene Ledenvergadering GroentenFruit Huis (contributie)


Op donderdag 10 oktober 2024 vond de jaarlijkse Nationale Groente- en Fruitdag plaats. Sinds een aantal jaar maakt deze dag onderdeel uit van de Week van Ons Eten.
Ter voorbereiding hebben we een toolbox ontwikkeld, met voorbeeldberichten en -foto’s die bedrijven en organisaties konden gebruiken voor hun eigen social media kanalen.
Op de dag zelf was er opnieuw veel aandacht voor groenten en fruit. Het is duidelijk een thema waar bedrijven en organisaties makkelijk op inspelen en dat hebben we gezien aan de hoeveelheid berichten die die dag op social media verschenen.
De Week van Ons Eten 2024 heeft bovendien een recordbereik behaald: maar liefst 69 miljoen mensen werden bereikt, met een PR-waarde van €2,18 miljoen.

Voedselbanken Nederland, GroentenFruit Huis, Groente & Fruitbrigade en Groentebrigade Manna hebben een intentieovereenkomst getekend om de toegang tot vers en gezond voedsel voor mensen in armoede te vergroten. Vicevoorzitter Tom Hillemans van Voedselbanken Nederland en voorzitter Cathy van Beek van GroentenFruit Huis bezegelden de overeenkomst met een handdruk.
De betrokken partijen willen de distributie en consumptie van vers en gevarieerd voedsel voor deze mensen vergroten door enerzijds het aanbod te vergroten en bedrijven aan te moedigen mee te doen om meer groenten en fruit beschikbaar stellen, en anderzijds door de gezondheidsaspecten en het gebruiksgemak te bevorderen.
Elke organisatie pakt haar rol: GroentenFruit Huis roept haar leden op om samen te werken, terwijl Groente & Fruitbrigade en Groentebrigade Manna zorgen voor een vlotte aansluiting van telers en handelaren. Voedselbanken Nederland zorgt ervoor dat het gezonde voedsel bij de klanten terechtkomt en biedt informatie over bereiding en gezonde keuzes.
Binnen drie jaar streven de partijen naar een duurzame oplossing, zodat het doneren van groenten en fruit de norm wordt in de sector.

In september 2024 is een programma gestart rond de Nieuwe Lunch Cultuur. GroentenFruit Huis, BeBright, Greenport West-Holland en de Provincie Zuid-Holland hebben de handen ineengeslagen om te werken aan een gezondere lunchcultuur. In dit acht maanden durende programma worden werkgevers ondersteund bij het realiseren van een gezonde lunch binnen hun organisatie.
Tijdens maandelijkse bijeenkomst worden bedrijven meegenomen aan de hand van diverse thema’s. Zo vond in september de kick-off plaats in het Provinciehuis van Zuid-Holland, en in november werd een sessie gehouden in het stadion van ADO Den Haag. Tijdens de kick-off werd er met behulp van Design Thinking gewerkt aan de ambities van de deelnemende organisaties. In november werd het plan van aanpak verder uitgewerkt. Gedurende het programma worden ook gastsprekers uitgenodigd om kennis te delen. Het programma loopt in 2025 verder door.

Dinsdagmiddag 25 juni 2024 namen 40 wethouders en ambtenaren deel aan een zonnige Straat Safari in Boskoop, tijdens het VNG Jaarcongres. GroentenFruit Huis, Greenports Nederland, Greenport West-Holland en HAS green academy organiseerden deze unieke ervaring namens de Tafel Gezonde Mensen van het Tuinbouwakkoord.
Met zorgwekkende trends zoals de toename van fastfoodrestaurants en de afname van gezonde voedselkeuzes bij jongeren, wilden we gemeenten inspireren en ondersteunen in hun streven naar een gezondere voedselomgeving.
Onder begeleiding van experts Herman Peppelenbos, Dr. Birthe Jongeneel-Grimen en Naomi Jansen, verkenden de deelnemers de voedselomgeving van een winkelstraat in Boskoop en gingen in gesprek met bewoners en lokale ondernemers. Ze kregen vervolgens tips en tools om de omgeving gezonder te maken.
De belangrijkste learnings uit de sessie:

In 2024 heeft GroentenFruit Huis collectief gewerkt aan de voorbereiding op de aanstaande wetgeving voor de Corporate Sustainability Reporting Directive (CSRD). Het doel van deze collectieve aanpak was om de deelnemende leden voor te bereiden op de wetgeving en tegelijkertijd de risico’s en kansen van de sector in kaart te brengen. Door samen te werken hebben we een enorme efficiëntieslag kunnen maken in zowel de inzet van mensen als de kosten voor de deelnemers. Bovendien leidde het onderlinge uitwisselen van kennis tot veel waardevolle inzichten.
CSRD project met PwC
Het eerste half jaar van 2024 stond in het teken van het sectorale CSRD project. Maar liefst 31 leden van GroentenFruit Huis werkten gezamenlijk aan de eerste stappen richting een CSRD rapportage: de dubbele materialiteitsanalyse (DMA). Via een uitgebreid proces, waarbij de verschillende bedrijfsperspectieven werden meegenomen, doorliepen de deelnemers de analyse om de meest relevante thema’s voor zowel de sector als de individuele bedrijven te identificeren.
PwC bracht inhoudelijke expertise in, terwijl GroentenFruit Huis de coördinatie verzorgde en daarmee zorgde voor de voortgang en borging van de resultaten. Gedurende meer dan 20 bijeenkomsten, zowel fysiek als online, werden de deelnemers stap voor stap door de DMA- en gap-analyse geleid. De uitkomsten van de DMA werden vervolgens getoetst door GroentenFruit Huis in samenwerking met negen sectorstakeholders, waaronder banken, retailers, een NGO en andere brancheverenigingen.
De resultaten van het project bieden waardevolle inzichten in de belangrijkste duurzaamheidsthema’s op milieu-, sociaal- en bestuurlijk niveau voor bedrijven. Deze inzichten kunnen bedrijven helpen hun duurzaamheidsbeleid verder vorm te geven en strategische keuzes te maken voor de toekomst. Ook heeft het project belangrijke informatie opgeleverd over de impact van de sector, evenals de risico’s en kansen die daarbij horen.
Het sectorale CSRD-project van GroentenFruit Huis is meerdere malen gepresenteerd als voorbeeld voor andere sectoren, onder andere in een webinar van de Sociaal-Economische Raad (SER). De groente- en fruitsector wordt door organisaties zoals VNO-NCW en het ministerie van Economische Zaken gezien als voorloper in de implementatie van de CSRD.
Na de afronding van het CSRD-project in juni werd onderzocht hoe GroentenFruit Huis de leden blijvend kan ondersteunen bij de implementatie van de CSRD. Dit leidde tot de oprichting van de werkgroep CSRD, die zich richt op het identificeren van kansen en knelpunten voor een efficiënte CSRD implementatie en verduurzaming binnen de sector.
Uit de analyse kwam naar voren dat het voor veel bedrijven een uitdaging was om de vertaling te maken van materiële onderwerpen naar een rapportage. Dit leidde tot een vervolgtraject, in samenwerking met Kroll Sustainability, waarbij een raamwerk is ontwikkeld waarmee leden eenvoudig de vertaling kunnen maken van materiële onderwerpen naar de te rapporteren datapunten.
Een andere kans die sectoraal opgepakt kan worden is het uniform in beeld brengen van de footprint, van zowel Nederlandse als geïmporteerde producten. In 2024 is GroentenFruit Huis gestart met de verkenning van hoe deze projecten efficiënt opgepakt kunnen worden. Beide projecten zullen in 2025 verder in gang worden gezet.
Begin december vond de eerste succesvolle CSRD netwerkbijeenkomst plaats, met meer dan 40 deelnemers. De middag stond in het teken van kennisdeling, inspiratie en netwerken.
Ondanks de verscheidenheid aan bedrijfstypes en de complexiteit van de wetgeving hebben we deze uitdagingen succesvol aangepakt en samen stappen gezet richting de implementatie van CSRD en verduurzaming van de sector.
Op 16 december 2024 werd de definitieve tekst van de Packaging & Packaging Waste Regulation (PPWR) aangenomen, en op 22 januari 2025 werd deze gepubliceerd. De PPWR is een wetsvoorstel gericht op het reduceren van verpakkingen en verpakkingsafval binnen Europa en het stimuleren van de recycling van verpakkingen. De volgende punten uit de wet zijn specifiek van belang voor onze sector:
Mede door inspanningen van GroentenFruit Huis op dit dossier hebben we een verbod op alle eenmalige groente- en fruitverpakkingen van minder dan 1,5 kg aangepast naar een verbod op eenmalige kunststof verpakkingen van meer dan 1,5 kg. Bovendien is de implementatie uitgesteld van 2028 naar 2030, zodat ondernemers meer tijd hebben om zich voor te bereiden.
GroentenFruit Huis pleit ervoor dat er één uniforme lijst komt met uitgezonderde producten voor alle lidstaten, zonder dat elke lidstaat hier zijn eigen invulling aan kan geven. Samen met onze Europese zusterorganisaties en koepelorganisaties proberen we een sectorale lijst van uitzonderingen op te stellen, die vervolgens met de Europese Commissie zal worden besproken. Het doel hiervan is om de handel tussen verschillende lidstaten te vergemakkelijken, geharmoniseerde wetgeving op dit vlak is daarbij cruciaal.
Om dit te bereiken moeten eerst de criteria en grenswaarden worden ingevuld (bijvoorbeeld: hoeveel procent vochtverlies bij een bepaald product zonder plastic verpakking is nog acceptabel, en waar ligt de grens?). De PPWR definieert momenteel een aantal criteria op basis waarvan producten kunnen worden uitgezonderd van het verbod op plastic verpakken, zoals vochtverlies. Het is echter nog onduidelijk hoeveel vochtverlies een uitzondering rechtvaardigt. Hierover is GroentenFruit Huis nog in gesprek met de Europese Commissie. Zodra hierover consensus bereikt is, moet worden vastgesteld welke producten, op basis van deze criteria, op de lijst met uitzonderingen terecht moeten komen. In 2025 zal GroentenFruit Huis verder werken aan dit proces, met als doel een zo geharmoniseerd mogelijke lijst van producten te creëren die uitgezonderd worden van het verbod op eenmalige plastic verpakkingen.
GroentenFruit Huis kritisch op SUP-wetgeving
De Europese Single Use Plastics-richtlijn uit 2019 is bedoeld om de milieu-impact van plastic zwerfafval te verminderen. Nederland heeft deze richtlijn vertaald in de Regeling kunststofproducten voor eenmalig gebruik, die op 1 juli 2023 van kracht is gegaan voor consumptie onderweg, en op 1 januari 2024 voor consumptie ter plaatse.
Het doel van deze regeling is het verminderen van het gebruik van eenmalige bekers en voedselbakjes die geheel of gedeeltelijk van plastic zijn gemaakt. Voor consumptie ter plaatse is hergebruik de norm, terwijl voor consumptie onderweg (inclusief voorverpakte producten in de supermarkt die onder de SUP-definitie vallen) een meerprijs geldt.
In de tweede helft van 2024 hebben Arcadis, Berenschot en Ipsos een evaluatie van de SUP-wetgeving uitgevoerd, waaraan GroentenFruit Huis ook heeft meegewerkt. Een belangrijk punt van kritiek vanuit GroentenFruit Huis en andere organisaties was dat het niet zinvol is om een meerprijs te vragen voor de eenmalige kunststofverpakking bij voorverpakte producten in de supermarkt waarvoor geen alternatief bestaat (zoals kunststof bakken met maaltijdsalades). De consument heeft in dit geval namelijk geen keuze voor een alternatieve verpakking, zoals ‘bring your own’.
De staatssecretaris heeft deze kritiek ter harte genomen en besloten dat de meerprijs voor voorverpakte producten in de supermarkt per 1 januari 2026 zal worden afgeschaft.
In de afgelopen jaren is GroentenFruit Huis betrokken geweest bij het opstellen en updaten van de beslisboom Duurzaam Verpakken Groente- en Fruitsector. In 2024 is gewerkt aan de doorontwikkeling van deze beslisboom naar een online tool: het Dashboard Duurzaam Verpakken.
Dit dashboard helpt een ondernemer bij het stellen van doelen voor verduurzaming van zijn verpakkingen, het analyseren van de huidige verpakkingen in het bedrijf (ook in relatie tot een referentieverpakking), het kiezen van een strategie om verpakkingen te verduurzamen en het opstellen van een dossier dat voldoet aan de wettelijk verplichte Essentiële Eisen.
In 2024 heeft GroentenFruit Huis, samen met het Kennisinstituut Duurzaam Verpakken en Partners for Innovation, gewerkt aan de verdere ontwikkeling naar een online tool waarmee bedrijven aan de slag kunnen bij het verduurzamen van hun verpakkingen. De tool zal in het voorjaar van 2025 gelanceerd worden en onder de aandacht gebracht bij de bedrijven in de groente- en fruitsector.

Afgelopen jaar is GroentenFruit Huis druk bezig geweest met de verdere ontwikkeling van de FreshProduce PEFCR. GroentenFruit Huis neemt namens de leden deel aan een consortium van zowel Nederlandse partners, zoals Glastuinbouw Nederland, Rabobank, ABN AMRO, AQS en Royal FloraHolland alsook Europese partners zoals Freshfel Europe, Greenyard en Dole, en kennispartners Wageningen University, PRé Sustainabilty en Meríeux NutriSciences | Blonk.
In 2024 zijn belangrijke stappen gezet in de verdere ontwikkeling van de methode, onder andere door twee ondersteunende studies om de methode in de praktijk te testen. Daarnaast heeft in 2024 de eerste publieke consultatie plaatsgevonden, waarbij de methode open is gesteld voor feedback. De consultatie werd afgetrapt met een webinar, dat meer dan 100 deelnemers uit de Europese sector en kennispartners trok. De publieke consultatie heeft meer dan 220 opmerkingen van 16 partijen opgeleverd, die nauwkeurig zijn beoordeeld en, waar relevant, verwerkt in de methode.
In 2025 zal de tweede publieke consultatie plaatsvinden, waarna de methode in april 2025 afgerond en gepubliceerd zal worden. Hiermee zetten we de standaard voor de sector neer.
Ook zijn er veel gesprekken gevoerd en bijeenkomsten gehouden om de sector en retailers te informeren over de methode en te zorgen voor adoptie van deze methode. Hier zal in 2025 volop mee doorgegaan worden.

GroentenFruit Huis werkt samen met sectorpartijen LTO, BO Akkerbouw, Royal Floraholland en Initiatief Duurzame Handel (IDH) aan de praktische toepassing van de concept methode Milieu Indicator Gewasbeschermingsmiddelen (MIG), die in publiek private samenwerking (PPS) is ontwikkeld. De MIG moet boeren en telers helpen de milieu-impact van gewasbeschermingsmiddelen beter te sturen. Na afronding van de PPS bleek de MIG als methode veel potentie te hebben, maar nog niet klaar voor de praktijk, vanwege een ontbrekende centrale database met de werkzame stoffen van gewasbeschermingsmiddelen en ook de rekenregels waren nog niet helemaal compleet.
In 2024 heeft GroentenFruit Huis samen met de genoemde partijen gewerkt aan het in kaart brengen van wat er nog nodig is om de MIG naar de praktijk te brengen en hoe dit gerealiseerd zou kunnen worden. Bovengenoemde partijen hebben Greenports Nederland verzocht om namens de partijen op te treden als penvoerder. Het is in 2024 gelukt om, in samenwerking met Schuttelaar & Partners, de financiële dekking voor het plan rond te krijgen. In 2025 wordt gestart met de afronding van de MIG, die in 2026 operationeel en klaar voor gebruik zal zijn.

Een van de grootste knelpunten voor de efficiënte werking van de EU-markt voor groenten en fruit is de variëteit aan eisen van verschillende retailers, vooral op het gebied van duurzaamheid maar ook voedselveiligheid. GroentenFruit Huis zet zich daarom in voor de harmonisatie van duurzaamheidseisen. Een belangrijke stap hierin is de ontwikkeling van een geharmoniseerde methode FreshProduce PEFCR, die de milieu-impact van groenten en fruit in kaart brengt.
Het ontwikkelen van een methode alleen is echter niet genoeg. We moeten af van de overvloed aan certificaten op de markt en overstappen naar een systeem waarin verschillende certificaten kunnen benchmarken, zodat telers niet langer alle certificaten hoeven te behalen. De PEFCR kan hierin een belangrijke rol spelen.
Daarom werkt GroentenFruit Huis, in samenwerking met UNIDO, aan een systeem voor de onderlinge erkenning en benchmarking van certificaten.
Ook neemt GroentenFruit Huis deel aan de werkgroep milieufootprint van het ministerie van Landbouw, Visserij, Voedselzekerheid en Natuur (LVVN), waar gewerkt wordt aan een geharmoniseerde methode om de milieu-impact van alle voedsel op te meten op basis van de PEF-methode. Er wordt ook gewerkt aan een label om de milieu-impact van voedselproducten transparant en vergelijkbaar te maken.
Daarnaast heeft GroentenFruit Huis in 2024, op verzoek van leden, een bezoek gebracht aan retailers in het VK om te praten over de standaardisatie van duurzaamheid.
Al met al is er veel inspanning geleverd om de certificeringsdruk op de leden te verlagen. Het veranderen van het certificeringssysteem is echter een complexe uitdaging die veel tijd en moeite vergt. GroentenFruit Huis blijft zich in 2025 inzetten om de lastenbeheersing op het gebied van certificering en andere retail-eisen te verlichten.

Ondermijning
In 2024 is de start gemaakt met het Landelijk Platform Ondermijning Groenten en Fruit. Speerpunten zijn preventie en bewustwording binnen de sector, bijvoorbeeld door training, selectiestrategieën en aandacht voor veiligheidsprotocollen op het bedrijf. Vanuit het platform wordt aansluiting gezocht bij lokale initiatieven, zoals in de Supply Chain Valley en Dutch Fresh Port. In de haven van Rotterdam is veel aandacht voor ondermijning, maar in het achterland is er nog veel te winnen.
Daarnaast is GroentenFruit Huis aangesloten bij de Expertcommissie Criminaliteitsbestrijding (VNO-NCW) en het Information Sharing Centre Achterland (TLN). Vanuit VNO-NCW doet GroentenFruit Huis mee aan het project Weerbare Branches. De output van dit project is een toolkit voor de sector om binnen het bedrijf acties te ondernemen ten behoeve van de veiligheid van het personeel. In 2025 zal het project worden uitgevoerd.
Logistiek
In samenwerking met Havenbedrijf Rotterdam, douane en bedrijven is het importproces ten aanzien van drugscontrole geoptimaliseerd. Hierdoor zijn extreme vertragingen bij containerscans gereduceerd. Op dit moment wordt ruim 95% van de scans binnen 36 uur afgehandeld. Middels een dashboard worden nu ook de fysieke controles verder geoptimaliseerd. Ook in 2024 is aan dit project gewerkt. Door kapotte scans en storingen zijn eind 2024 oplopende doorlooptijden geconstateerd. Reden genoeg om in 2025 opnieuw aandacht te vragen voor dit proces. Hetzelfde geldt voor de Haven van Vlissingen.
Via Greenports Nederland en het programma Goederenvervoercorridor heeft GroentenFruit Huis een bijdrage geleverd aan drie speerpunten: verduurzaming van het wegvervoer, modal shift (vers op spoor) en digitalisering. Met name Vers op het Spoor heeft aandacht gekregen, onder andere op handelsbeurzen. Digitalisering is mede opgepakt is samenwerking met zusterbrancheorganisaties, waarbij de importketen van sinaasappels uit Egypte centraal staat. Laaghangend fruit is in kaart gebracht en samen met de NVWA en de douane zullen oplossingen worden uitgewerkt. Portbase, als dataplatform, speelt hierbij een belangrijke rol.

GroentenFruit Huis zet zich dagelijks in om regelgeving en processen van toezicht, uitgevoerd door KCB en de NVWA, zo gunstig mogelijk voor de sector te maken. De belangrijkste onderwerpen worden hieronder beschreven.
Uitwerking aanbevelingen evaluatie RIK en Structureel Toezicht KCB
GroentenFruit Huis is betrokken geweest bij de uitwerking van de aanbevelingen die voortkwamen uit de evaluatie van de bovengenoemde regelingen. In de loop van 2024 zijn meerdere punten uitgewerkt, zoals een update van het handhavingsdocument, waarbij het aantal handhavingspunten omhoog is bijgesteld.
NVWA- retributie
GroentenFruit Huis heeft bereikt dat de discussie over het ongelijk speelveld met LVVN opnieuw gevoerd kan worden. Toezicht en de bijbehorende tarieven hebben een negatieve invloed op de concurrentiepositie van NL BV. Het Kabinet heeft wel de activiteiten van de NVWA kostprijsdekkend gemaakt, maar kijkt onvoldoende naar de economische impact voor het bedrijfsleven. Hier is nu eindelijk meer aandacht voor. Efficiëntie van kosten en doorlooptijden blijven belangrijke discussiepunten. GroentenFruit Huis heeft bedongen dat met de NVWA overleg zal plaatsvinden over de doelmatigheid van toezicht in de plantaardige sectoren. Inmiddels hebben enkele bijeenkomsten plaatsgevonden, waarbij onderwerpen als ’transparante communicatie’, databeheer en de hoge kosten voor het inklaren van hoog-risico fytosanitair product besproken zijn.

GroentenFruit Huis heeft, als vervolgstap op het eerdere Woo-verzoek (Wet open overheid), een beroep ingediend bij de Rechtbank Den Haag om meer openbaarheid en onderbouwing te verkrijgen van de Nederlandse Voedsel- en Warenautoriteit (NVWA) met betrekking tot de behandeling van hoog-risico producten. Het uiteindelijke doel van dit verzoek is het verkrijgen van toestemming voor het gebruik van private laboratoria voor de analyse van deze producten, met als voordelen kostenbesparing en verkorting van de doorlooptijd.
Tegelijkertijd voert GroentenFruit Huis gesprekken met de overheid (LVVN en VWS) over de reden waarom de analysekosten zo hoog zijn en of het volgens EU-regelgeving toegestaan is om een privaat laboratorium in te zetten.
Er is aangegeven dat juridisch gezien de NVWA een privé-laboratorium zou mogen aanwijzen, maar dat dit vanwege onafhankelijkheidsvereisten niet gebeurt. GroentenFruit Huis heeft aangegeven dat de EU-regelgeving de gevraagde onafhankelijkheid niet vereist. De discussie over deze kwestie is echter nog niet afgerond.

Het EU-beleid wordt bepaald door de 27 lidstaten, waarbij de stemverhouding is gebaseerd op het inwonersaantal. Dit betekent dat Nederland relatief een kleine stem heeft in de besluitvorming in Brussel. De positie van Nederland is verder verslechterd door de Brexit, doordat het Verenigd Koninkrijk, dat voorheen een belangrijke medestander was op veel dossiers, nu niet meer als speler aanwezig is.
De vorming van nieuwe allianties met EU-lidstaten en samenwerking binnen internationale overlegstructuren staat dan ook hoog op de agenda van GroentenFruit Huis. Het doel is het zoeken naar gemeenschappelijke belangen, zoals onder andere voedselzekerheid en productbeschikbaarheid.

Thailand
De EU is gezamenlijk met enkele lidstaten begonnen aan een markttoegangstraject voor peren naar Thailand. Er heeft een audit plaatsgevonden, waarna in februari 2024 het officiële bericht over de markttoegang gepubliceerd is en er toestemming verleend werd voor de import van Nederlandse peren. Nederland heeft hierbij in vergelijking gunstigere eisen gekregen dan andere lidstaten. Dit is mede dankzij bestaande monitoringsprotocollen en lopende markttoegangserkenningen die extra vertrouwen gaven in hoe zorgvuldig de Nederlandse telers en toezichthouders omgaan met fytosanitaire risico’s. Deze toegekende markttoegang betekent dat vanuit Nederland nu een compleet assortiment hardfruit geleverd kan worden aan Thailand. Dit is een van de vele verre bestemmingen voor Nederlands hardfruit die gezamenlijk een belangrijk onderdeel vormen van onze export naar derde landen.
Indonesië
Eind 2023 werd onverwacht de grens voor Nederlandse uien naar Indonesië gesloten. Ook andere exporterende landen werden getroffen door deze plotselinge maatregel. De aanleiding hiervoor was een nieuwe eis dat geïmporteerde uien behandeld moesten worden met methylbromide. Deze behandeling is echter verboden binnen de Europese Unie en vele andere landen.
Er zijn spoedig onderhandelingen gestart tussen Nederland en Indonesië om de markt te heropenen. Als onderdeel hiervan heeft een Indonesische delegatie een bezoek gebracht aan de Nederlandse uiensector om zelf inzicht te krijgen in de hoge kwaliteitsstandaarden, fytosanitaire controles en alternatieve maatregelen die Nederland hanteert. Dankzij de gezamenlijke inspanningen van het bedrijfsleven, LVVN en NVWA kon de markt midden in het belangrijke exportseizoen weer geopend worden. Op dit moment is Nederland daardoor een van de weinige landen die opnieuw toegang heeft gekregen tot de Indonesische markt voor uien.
Knelpunten en bedreigingen import
Op initiatief van het Comité Import Export Derde Landen (CIEDL) is in 2024 gestart met een uitgebreide inventarisatie van alle import knelpunten en bedreigingen voor de komende vijf jaar, aan de hand van een enquête en brainstormsessie. In 2025 vindt een verdere uitwerking plaats om te komen tot een strategisch actieplan per onderwerp en het bepalen van eventuele prioriteiten. Productbeschikbaarheid is in het Jaarplan 2025 van GroentenFruit Huis als één van de drie hoofdprioriteiten benoemd.
Asperge
De in 2023 opgerichte Asperge werkgroep, naar aanleiding van aanscherping EU beleid, is in 2024 actief voortgezet doormiddel van regulier overleg, bijeenkomsten in Berlijn en Madrid (met o.a. autoriteiten exporterende landen), overleg met Wageningen Universiteit over mogelijk onderzoek, en het opzetten van een strategie richting de EU. In de werkgroep wordt samengewerkt door importeurs uit diverse lidstaten, Freshfel, GroentenFruit Huis en Fresh Trade Belgium, en zijn korte lijntjes met de Nederlandse autoriteiten.

Het werd al snel duidelijk dat de loonontwikkeling nog steeds een hoofdthema was binnen de onderhandelingen. Door de forse stijgingen van het minimumloon in de afgelopen twee jaren, stijgen de loonkosten aanzienlijk en wordt het loongebouw aan de onderkant behoorlijk in elkaar geschoven. Dit stelde het Comité Cao voor weer een paar flinke uitdagingen. Het was echter belangrijk om andere aspecten, zoals duurzame inzetbaarheid, niet uit het oog te verliezen.
Door het open en constructieve overleg is het sociale partners gelukt om tot goede afspraken te komen. Naast een structurele loonsverhoging van 3,1% per 1 juli 2024 en van 3% per 1 januari 2025, zijn er afspraken gemaakt over o.a. de hoogte van de reiskostenvergoeding en de opbouw van de vakantietoeslag. Daarbij is er ook specifiek aandacht geweest voor duurzame inzetbaarheid en de verschillende doelgroepen, zoals jongeren, chauffeurs en AOW-gerechtigden.
De leden van de vakbonden stemden positief over het behaalde onderhandelingsresultaat, waarna een nieuwe cao per 1 juli 2024 van kracht ging.

Per 1 januari 2027 vindt de transitie van het pensioenstelsel (Wet Toekomst Pensioenen) plaats. Het definitieve transitieplan moest uiteindelijk voor 1 juli 2024 door sociale partners worden aangeleverd bij PGB. In het jaar 2024 stond de pensioentransitie dan ook hoog op de agenda. Het traject van sociale partners begon al in 2023, maar in 2024 zijn sociale partners tot een transitieplan gekomen.
Zowel in mei, op de themamiddag, als in oktober, is er een informatiesessie geweest over de pensioentransitie. GroentenFruit Huis heeft in mei met haar leden het voorstel van de te maken afspraken besproken. Tijdens de tweede sessie werden de deelnemers bijgepraat over de gemaakte afspraken met vakbonden met betrekking tot de overgang van de huidige basisregeling bij PGB naar het nieuwe pensioenstelsel. Er werd uitgebreid ingegaan op het doorlopen proces, de inhoud van de afspraken en de mogelijke vervolgstappen die organisaties moeten nemen, vooral wanneer er sprake is van dispensatie of een excedent regeling.

In 2024 is de Young Business Club, een initiatief van GroentenFruit Huis om jonge professionals uit de groente-en fruitsector met elkaar te verbinden, meerdere malen samengekomen.
Tijdens de eerste bijeenkomst in mei, met het thema ‘Proef Plantaardig!’, kregen deelnemers een rondleiding door de innovatieve kassen van Koppert Cress, inclusief een kijkje in hun startup breeder Division Q. Vervolgens bood NGIN inzichten over talentontwikkeling bij jongeren, terwijl InstockMarket een interactieve workshop over de aanpak van voedselverspilling leidde. De geslaagde bijeenkomst, die werd afgesloten met een plantaardige borrel, combineerde kennisdeling, netwerken en inspiratie voor de sector.
De Young Business Club was in november op bezoek bij Verstegen Spices & Sauces in Rotterdam voor een bijeenkomst over ‘Sourcing: Duurzaam inkopen en slimme ketens’. Verstegen deelde haar aanpak voor duurzaamheidsmanagement en leveranciersmonitoring binnen hun wereldwijde netwerk, terwijl Slimstock inzichten bood over voorraadoptimalisatie en toekomstbestendige ketens. Na de presentaties namen deelnemers deel aan de Supply Chain Game, waarbij ze een handelsketen simuleerden om voorraadbeheer te optimaliseren. De middag werd afgesloten met netwerken in het Experience Centre van Verstegen, waar jonge professionals ervaringen uitwisselden over uitdagingen in hun eigen organisaties.

De notificatieplicht voor laboratoria komt voort uit actieplan Voedselveiligheid en de verbeterplannen na de fipronil-crisis. Het argument vanuit VWS/NVWA in 2018 was dat een dergelijke notificatieplicht voor de diervoedersector al nationaal verplicht is, maar nog niet voor de levensmiddelensectoren. De notificatieplicht wordt opgezet als extra handhavingsinstrument voor de NVWA, zodat er een match kan worden gemaakt tussen de meldingen van onveilige levensmiddelen door bedrijven en laboratoria. Het doel is de naleving van de meldplicht te verbeteren.
Sinds de eerste uitwerkingen maken we ons echter zorgen dat de invoering van een algemene notificatieplicht voor private laboratoria een averechts effect zal hebben op
de risicogerichte borging van voedselveiligheid door voedselproducenten. De notificatieplichtis ingegeven door wantrouwen van de overheid/NVWA, zonder dat het directe meerwaarde biedt voor het vergroten van voedselveiligheid of het verbeteren van het proces van terugkoppeling naar bedrijven.
Vanuit GroentenFruit Huis is benadrukt dat het uitvoeren van onderzoeksprogramma’s en sectorale monitoring, zoals deze door Food Compass worden gedaan, mogelijk moeten blijven en uitgezonderd moeten worden.
In opdracht van VWS loopt er onder leiding van de NVWA een project met de opzet en implementatie in zes werkgroepen, waarin ook de levensmiddelensectoren en laboratoria
vertegenwoordigd zijn. In 2024 is een voorlopige scope vastgesteld en is een lijst opgesteld met ruim 40 mogelijke (ongewenste) neveneffecten, gekoppeld aan de processtappen. Zoals kostenverhoging, uitwijken naar het buitenland, minder analyses of het afzien van analyses.
Door de gezamenlijke inzet vanuit platform Voedselveiligheid in alle werkgroepen en de kerngroep is het project in de uitwerking en opzet aanzienlijk aangepast, met meer aandacht voor neveneffecten, praktijkcasussen en kwantificering. Ook in 2025 loopt het project nog door, en na de afronding volgt de eindrapportage, waarna de uitwerking in wettelijke basis zal plaatsvinden.
De deelnemers van Food Compass verzamelen data over residuen van gewasbeschermingsmiddelen, microbiologie op verse producten en watergebruik in de teelt. Deze waardevolle gegevens worden ingezet in diverse onderzoeksprogramma’s, samen met de WUR, maar ook de Hogeschool Leiden en de Universiteit van Gent.
Zo is er een vervolg gestart op een eerdere PPS, waarbij gekeken wordt naar de impact van gecombineerde blootstelling aan resten van gewasbeschermingsmiddelen op levensmiddelen. Naast groenten en fruit wordt nu ook verder doorgerekend met zuivel, aardappelen en noten/zuidvruchten. Het doel is om sectorbreed proactief ervaring op te doen met de methodiek en inzicht te krijgen in de gezondheidseffecten van de stapeling van residuen van gewasbeschermingsmiddelen.
In het contaminantenonderzoek, dat vanuit GroentenFruit huis wordt gefinancierd, zijn analyses gedaan voor zware metalen, perchloraat en nitraat. In de afgelopen jaren is steeds hetzelfde mandje groenten en fruit bemonsterd en geanalyseerd.
In het project van Hoge School Leiden, Advanced Precision in Food Safety, wordt gericht op het snel identificeren van L. monocytogenes, Salmonella en STEC bacteriën met DNA-technieken. Het sequencen van DNA van deze bacteriën aan het begin van diverse voedselverwerkingsketen in de productieomgeving, maar ook in grondstoffen, zoals uit het microbiologisch onderzoeksprogramma van Food Compass, wordt geanalyseerd met behulp van bio-informatica om transmissieroutes te achterhalen. Dit project biedt een unieke kans om de voedselveiligheid te verbeteren en samen te werken met diverse partners in andere sectoren.
Deelname aan Food Compass door leden van GroentenFruit Huis is belangrijk: niet alleen om een representatief beeld van de sector te krijgen, maar ook door de analyseresultaten in te zetten voor het vergaren van nieuwe kennis ten dienste van de hele sector.
Op 11 juni organiseerden GroentenFruit Huis en Food Compass een kennisbijeenkomst over voedselveiligheid, met ruim 70 deelnemers. Tijdens de bijeenkomst werden diverse actuele ontwikkelingen besproken.
Martien de Graaf (voorzitter Food Compass) benadrukte het belang van monitoring en data-analyse voor de voedselveiligheid van groenten, fruit en paddenstoelen, met GroentenFruit Huis als partner in de sectorlobby. Nicolette Quaedvlieg besprak de aangepaste meldwijzer van de NVWA, de invoering van de wettelijke notificatieplicht voor private laboratoria, en nieuwe wetgeving over microbiologie en contaminanten, zoals de maximale nikkellimiet voor groenten en fruit. Ook de resultaten van de residu- en microbiologische onderzoeksprogramma’s van Food Compass werden gepresenteerd door Robert Bakker. Verder sprak Lapo Mughini Gras (RIVM) over het beperkte aandeel van groenten en fruit in voedselinfecties (1-2%), gaven Charlotte ter Haar-Schröder en Marjan van Ravenhorst inzicht in de actuele wetgeving omtrent allergenen en het belang van preventie en risicobeoordeling bij de etikettering van allergenen op voedselproducten en Thomas Bock (Universiteit van Gent) presenteerde resultaten van een 10 jaar durend onderzoek naar microbiologische veiligheid.
De bijeenkomst bood waardevolle inzichten in de huidige uitdagingen en ontwikkelingen rondom voedselveiligheid in de groenten- en fruitsector. Meer lezen over de inhoud van de bijeenkomst kan op onze website.

Mede op verzoek van GroentenFruit Huis heeft Food Compass haar data over de periode 2013-2023 geanalyseerd. Uit tien jaar intensieve monitoring van verse, onbewerkte groenten, fruit en paddenstoelen blijkt dat de voedselveiligheid in Nederland op een consistent hoog niveau ligt. Meer dan 17.000 monsters werden onderzocht op de aanwezigheid van residuen van gewasbeschermingsmiddelen. Dit gebeurt via een sectorale, risicogestuurde monitoring, waarbij het handelsvolume en eerdere analyseresultaten bepalend zijn voor het aantal monsters per product. De jaarlijks 1.400 monsters geven inzicht in de voedselveiligheid door middel van monitoring en data-analyse.
Alle informatie kunt u vinden op de factsheet.

In het platform Voedselveiligheid is een Factsheet PFAs gemaakt naar aanleiding van verwarring over PFAS, ook binnen de voedingsmiddelenindustrie. In de factsheet worden een aantal zaken op een rijtje gezet: wat is PFAS eigenlijk en waarom is het een probleem? Welke regels zijn er en wat hebben gewasbeschermingsmiddelen er mee te maken?
Op 11 december 2024 vond de eerste expertbijeenkomst plaats voor leden van het Platform Voedselveiligheid, met als thema: ‘Circulair en Voedselveilig’. Tijdens deze bijeenkomst werd er uitgebreid ingegaan op de toekomst van verpakkingen en de uitdagingen op het gebied van recyclebaarheid, voedselveiligheid en duurzaamheid.
Knaagdierbestrijding is voor levensmiddelenbedrijven ook een steeds grotere uitdaging. De NVWA heeft in een webinar toegelicht hoe het Integrated Pest Management (IPM) zou moeten werken en de rol van de toezichthouders.
De uitkomsten van het PPS-project over ‘De rol van transmissieroutes water en mest bij besmetting van groente -en fruit productiesystemen met humaan pathogene bacteriën’ waren de aanleiding om dit in het Kennis op Maat-project te vertalen naar praktische handvaten voor telers.
In het webinar van 20 juni over de Wikipagina zijn de belangrijkste veranderingen voor microbiologische veiligheid in versie 6 van GLOBALG.A.P. uitgelegd.

productiewaarde groenten en fruit
lagere oogst van fruit in Nederland
importbedrag groenten (24%) en fruit (76%)
gekocht gewicht groenten en fruit per huishouden in Nederland
grotere consumentenaankoop biologische groenten en fruit in Nederland
gemiddeld betaalde prijs voor een kilo verse groenten en fruit
Ook in 2024 is er in Nederland sprake geweest van inflatie. Zowel de prijs van groenten als van fruit is hieraan onderworpen. De totale inflatie van groenten is 1,3% in 2024 en die van fruit 2,7%. In de tabellen hieronder staat een duidelijk overzicht van de inflatie per maand van groenten en fruit in 2023 ten opzichte van het jaar ervoor.
De Nederlandse consumptie van verse groenten en fruit viel in 2024 vergeleken met voorgaand jaar met 3 procent terug. Zowel thuisgebruik als consumptie in horeca en catering lag lager dan in 2023. Tomaat voert de lijst aan van meest gekochte groenten, terwijl banaan onder Nederlanders de meest gekochte fruitsoort is. Het verspakket wint nog altijd terrein in de supermarkt.

China
Importbedrag stijgt met 32% door meer knoflook en gember
Kenia
Door avocado’s stijgt importbedrag uit Kenia met 18%
Marokko
Verdubbeling importwaarde avocado’s naar ruim €50 mln
Chili
16% hogere import door meer blauwe bessen en druiven
India
Importbedrag stijgt met 18% door druiven
Brazilië
11% hogere import door mango’s en limoenen
China
Importbedrag stijgt met 32% door meer knoflook en gember
Kenia
Door avocado’s stijgt importbedrag uit Kenia met 18%
Marokko
Verdubbeling importwaarde avocado’s naar ruim €50 mln
Chili
16% hogere import door meer blauwe bessen en druiven
India
Importbedrag stijgt met 18% door druiven
Brazilië
11% hogere import door mango’s en limoenen

België
Grotere verkoop avocado’s en NL komkommers
Oostenrijk
16% hogere NL afzet in vergelijking met 2023; meer druiven, avocado’s en blauwe bessen
Dominicaanse Republiek
3x zoveel NL uien verkocht als in 2023
Verenigde Staten
Verkoop NL paprika stijgt van 3,5 mln kilo in 2023 naar 11 mln kilo in 2024
Spanje
9% hogere NL afzet vooral door druiven, avocado’s en tomaten
Verenigd Koninkrijk
Sterkere vraag naar NL tomaten (12+), maar 18% minder uien
Israël
7e afzetland voor NL uien (48 mln kilo)
België
Grotere verkoop avocado’s en NL komkommers
Oostenrijk
16% hogere NL afzet in vergelijking met 2023; meer druiven, avocado’s en blauwe bessen
Dominicaanse Republiek
3x zoveel NL uien verkocht als in 2023
Verenigde Staten
Verkoop NL paprika stijgt van 3,5 mln kilo in 2023 naar 11 mln kilo in 2024
Spanje
9% hogere NL afzet vooral door druiven, avocado’s en tomaten
Verenigd Koninkrijk
Sterkere vraag naar NL tomaten (12+), maar 18% minder uien
Israël
7e afzetland voor NL uien (48 mln kilo)

Nederland vervult een toonaangevende rol in Europa met peren. Samen met Italië en België staat Nederland in de top-3 productielanden van Europa. Op iets meer dan 10.000 hectare zijn perenbomen in ons land te vinden. Dit valt te lezen in de Factsheet peer in beeld van GroentenFruit Huis.

Vraag jij je af welke groenten hardlopers zijn in verspakketten? Zijn dat vooral producten als tomaat, bloemkool, paprika en ui? Het verspakket Indiase Tikka Masala en het verspakket Japanse teriyaki doen het goed in de Nederlandse supermarkt, maar wat zijn de ingrediënten en om hoeveel gewicht gaat het?
Door middel van een scraping tool ontwikkeld door het bedrijf Captain wordt er door GroentenFruit Huis meer inzicht verschaft in verspakketten. De jaarlijkse verkoop van verspakketten stijgt nog steeds.
De kans is heel groot dat in een willekeurig verspakket paprika, ui of knoflook wordt aangetroffen. De top-3 producten in verkocht gewicht uitgedrukt zijn tomaat, ui en paprika.
Meer informatie is te vinden in het dashboard marktinformatie groenten en fruit. Nog geen toegang? Zie in het hetzelfde linkje hoe je je kan aanmelden.

Wie is de shopper of eindconsument in Nederland van een groente- of fruitsoort? Wat zijn de gebruikstoepassingen? Wat zijn favoriete consumptiemomenten?
Dit zijn onderwerpen die onderzoeksbureau Hiiper exclusief in een onderzoek voor leden van GroentenFruit Huis tegen een aantrekkelijke prijs in kaart heeft gebracht. Hiermee is het mogelijk om de markt te begrijpen vanuit de shopper/eindconsument.
Er is ingeschreven op 13 verschillende producten. Het gaat om waardevolle shopper- en consumenteninzichten in Nederland op productniveau. Enkele onderzoeksvragen: wie is de koper van zoete paprika, wat is het imago van groene asperges, wanneer op de dag eet de Nederlander een appel, met welke groente wordt zoete aardappel veel gecombineerd?

Begin 2024 heeft GroentenFruit Huis, samen met Cyberweerbaarheidscentrum Greenport, alle leden de mogelijkheid geboden om gratis deel te nemen aan een Cyberscan van ieders openbare website(s).
Op basis van de websitenaam (www) en bedrijfsnaam is een meting uitgevoerd, door in openbare bronnen op het internet te kijken wat er over het bedrijf te vinden is en in hoeverre er kwetsbaarheden op basis van deze uitvraag gevonden kunnen worden. Dit is een belangrijke eerste stap, omdat een website en de e-mailadressen voor criminelen vaak een eerste toegangspoort tot de systemen zijn.

Het afgelopen jaar stond in het teken van verkenning en verdieping op het gebied van Artificial Intelligence (AI). Tijdens het derde GroentenFruit Huis Congres op Fort Wierickerschans in Bodegraven werd dit onderwerp uitgebreid belicht onder meer dan 135 deelnemers uit onze sector.
AI-expert Job van den Berg van ai.nl omschreef AI treffend als “statistiek met enorme spierballen” en benadrukte dat we aan de vooravond staan van een revolutie. Met name generatieve AI zal naar verwachting binnen vijf jaar een groot deel van onze huidige werkzaamheden transformeren. Van den Berg deelde concrete voorbeelden van bedrijven die AI al succesvol inzetten voor het optimaliseren van logistieke processen en het terugdringen van verspilling.
De toepassing van AI ging verder tijdens de workshops waarbij aandacht was voor de rol van AI bij het verkrijgen van marktinformatie en de toepassing van AI in voedselveiligheid.
De boodschap is helder: we moeten iets met AI, en nu is het moment om de eerste stappen te zetten.

Het jaar 2024 is voor velen een jaar van de omwenteling gebleken. Verkiezingen op nationaal (2023) en Europees niveau (2024) resulteren in een andere politieke wind Het nieuwe adagium is een politiek dichter bij de praktijk, met minder regels en administratieve lasten die worden aangepakt. In Europa wordt voedsel nadrukkelijker op de kaart gezet.
In de aanloop naar de Europese verkiezingen heeft het team Public Affairs van GroentenFruit Huis een aantal beoogde kandidaten voor het Europees Parlement ontvangen op locatie bij enkele van onze leden. Tijdens deze bijeenkomsten werden ook interviews afgenomen. Daarnaast organiseerden we, samen met andere Nederlandse tuinbouworganisaties, het Plantdebat. Door deze initiatieven hebben we de sector goed op (Europese) kaart gezet en zijn wij nu een gewaardeerde samenwerkingspartner voor de gekozen kandidaten.
Afgelopen jaar werd de toekomst van de agrarische en foodsector gedurende zeven maanden besproken door de Europese Commissie, onder leiding van voorzitter Ursula von der Leyen, samen met belangrijke stakeholders. GroentenFruit Huis heeft actief bijgedragen aan deze discussies.
De veranderende geopolitieke omstandigheden hebben geleid tot een tendens van protectionisme voor de Europese productie van agrarische producten. Tegelijkertijd groeit de vraag naar sterke, betrouwbare handelspartners, nu een verschillende landen (dreigen) importheffingen in te voeren.
In dit tijdsgewricht heeft GroentenFruit Huis zich zowel op nationaal als Europees niveau sterk gemaakt, rechtstreeks en via Europese lobbykoepels COPA-COGECA, Freshfel en AREFLH De inzet richtte zich op het verder optimaliseren van de afzetketen voor groenten en fruit. Daarnaast hebben we onze banden met andere Europese organisaties versterkt, waaronder Eurocommerce en CELCAA.
Gezien de internationale positie van de Nederlandse groente- en fruitsector is open handel van groot belang. Deze handel is echter niet meer vanzelfsprekend. We zetten met succes druk om WTO-regels te respecteren en termen als reciprociteit (spiegelclausules en wederkerigheid) tegen te gaan.
Om onze boodschap in Europa kracht bij te zetten, vormen we rondom dossiers strategische coalities en werken we in breder verband samen met nieuwe alliantie, zoals de delegatie van de agribusiness van Noordelijke lidstaten en Polen in Brussel. We bereiden een gezamenlijke strategische agenda voor, waarmee we collectief actie ondernemen.
Een belangrijk aandachtspunt na besluitvorming rondom Europese verpakkingsregels (PPWR), die een verbod op plastic verpakken behelst, is het voorkomen dat lidstaten eigen uitzonderingslijstjes creëren. Als lid van Freshfel en AREFLH heeft GroentenFruit Huis actief bijgedragen aan het opstellen van een geharmoniseerde EU-lijst, die wij aan de Europese Commissie hebben aangeboden.
Deze acties onderstrepen de proactieve rol die GroentenFruit Huis speelt in het versterken van de positie van de groente- en fruitsector op zowel nationaal als Europees niveau.

Met de vorming van het nieuwe kabinet zijn de contouren van het nationaal beleid duidelijk geworden. Er wordt ingezet op een pragmatische aanpak, die soms gepaard zal gaan met aanzienlijke bezuinigingen. Dit heeft gevolgen voor de agrarische sector, waarbij BTW verhogingen op de loer liggen. Dit terwijl in vrijwel alle verkiezingsprogramma de BTW op groenten en fruit naar 0% werd gepromoot.
Een belangrijke prioriteit op nationaal niveau voor GroentenFruit Huis is de aanpak van de zogenaamde “nationale koppen”. Dit verwijst naar de extra eisen die de Rijksoverheid stelt bovenop de verplichtingen vanuit de Europese Unie. Samen met VNO-NCW wordt er hard gewerkt aan het schrappen van deze ‘koppen’, met als focus onder andere het disproportioneel werkende optreden van de Nederlandse Voedsel- en Warenautoriteit (NVWA).

Voor ons Public Affairs werk maken we gebruiken van verschillende instrumenten en benaderingen. Naast social media en het laten uitvoeren van studies, zijn het bijwonen en soms zelf organiseren van evenementen essentieel om tegenstanders of medestanders te vinden, met hen in gesprek te gaan en waar nodig te mobiliseren. Deze evenementen worden zowel nationaal als internationaal georganiseerd en spelen een cruciale rol in het versterken van ons netwerk en invloed.
Een belangrijk onderdeel van ons werk in 2024 was de vertegenwoordiging in sociale dialogen met beleidsmakers, met name in Brussel. Door actief deel te nemen aan deze gesprekken kunnen we direct invloed uitoefenen op beleidsontwikkeling en -besluitvorming die van invloed zijn op onze sector.
Daarnaast zijn we dankbaar voor de leden die ons helpen met het ontvangen van bezoekers op de werkvloer. Door hen inzicht te geven in de dagelijkste praktijk van de sector, worden de uitdagingen en problemen direct zichtbaar en wordt het voor beleidsmakers duidelijker hoe zij hun beslissingen kunnen afstemmen op de realiteit van de sector.

Het Europese Gemeenschappelijk Landbouwbeleid (GLB) vormt binnen de EU en Nederland de basis voor het beleid op het gebied van groenten en fruit. In veel gevallen gaat het GLB verder dan alleen de productie, het bevat ook het beleid en regels met betrekking tot onder meer kwaliteitsnormen, de voorschriften voor de controle daarop, importheffingen en de wijze waarop deze worden vastgesteld (zoals de Standard Import Values, SIV), handelsverdragen en -wijzigingen (bijvoorbeeld met Marokko), en specifieke thema’s zoals promotieregelingen, schoolfruit en geografische oorsprongsbenamingen.
De inzet van GroentenFruit Huis was, zowel binnen Europa als binnen Nederland, gericht op het beschermen en borgen van de specifieke belangen van de Nederlandse groente- en fruitsector.
In 2024 heeft GroentenFruit Huis namens DPA, samen met de koepel van producentenorganisaties, actief bijgedragen aan de nadere invulling van het nationale GLB-beleid. Daarbij lag de nadruk op het programma voor de Gemeenschappelijke Marktordening (Groenten en Fruit), de Sectorale Interventie Groenten en Fruit (SIGF).
We hebben gepleit voor een effectief en toegankelijk beleid dat ruimte biedt om de energie-efficiëntie te verbeteren en duurzamere productiemethoden toe te passen. Hierdoor kunnen teeltbedrijven hun kosten verlagen en hun productie stabiliseren of jaarrond mogelijk maken. Dit maakt de sector minder kwetsbaar voor schommelingen in energieprijzen en andere externe factoren, wat bijdraagt aan de continuïteit van de aanvoer van Nederlandse groenten en fruit.
Daarnaast bleef promotie een belangrijk speerpunt. Binnen de kaders van het EU-promotiebeleid hebben we aandacht gevraagd voor voldoende middelen en heldere criteria, zodat Europese groente- en fruitcampagnes kunnen blijven bijdragen aan gezonde consumptie en een sterk imago van de sector.

GroentenFruit Huis is een vereniging met een bestuur.
De bestuursleden van GroentenFruit Huis vertegenwoordigen de diverse specialismen van leden zoals import, export, binnenlandse groothandel, bewerking, uien etc.
GroentenFruit Huis heeft deelnemingen in een aantal organisaties.
Zij leveren een bijdrage leveren aan het collectief belang van de sector. Dit zijn BO Groente en Fruit, Food Compass, Frug I Com, Stichting Afzetbevordering Ui, Stichting Food for Better Life Style en Stichting Holland Fresh Group.
Business Councils bestaan uit leden van GroentenFruit Huis.
Zij hebben een adviesrol naar de werkorganisatie. De Business Councils zijn gerelateerd aan de activiteiten van de vereniging, zoals het verzamelen van marktinformatie, bespreken van arbeidsgerelateerde ontwikkelingen, digitalisering of gezondheid.
(Net)werkgroepen bestaan uit leden die vanuit hun vakgebied meedenken over actuele onderwerpen.
Zo zijn er onder andere werkgroepen voor Verpakkingen, Kwaliteitsmanagers Groentebewerkingsbedrijven, PlanetProof. Het complete overzicht is te vinden op de website van GroentenFruit Huis.
Netwerkclubs stimuleren de leden van GroentenFruit Huis om te netwerken met collega’s uit de groente- en fruitsector.
Dit doen we door het organiseren van bijeenkomsten binnen de netwerkclubs: Young Business Club, Agri Ladies en AGF Trendcafé.